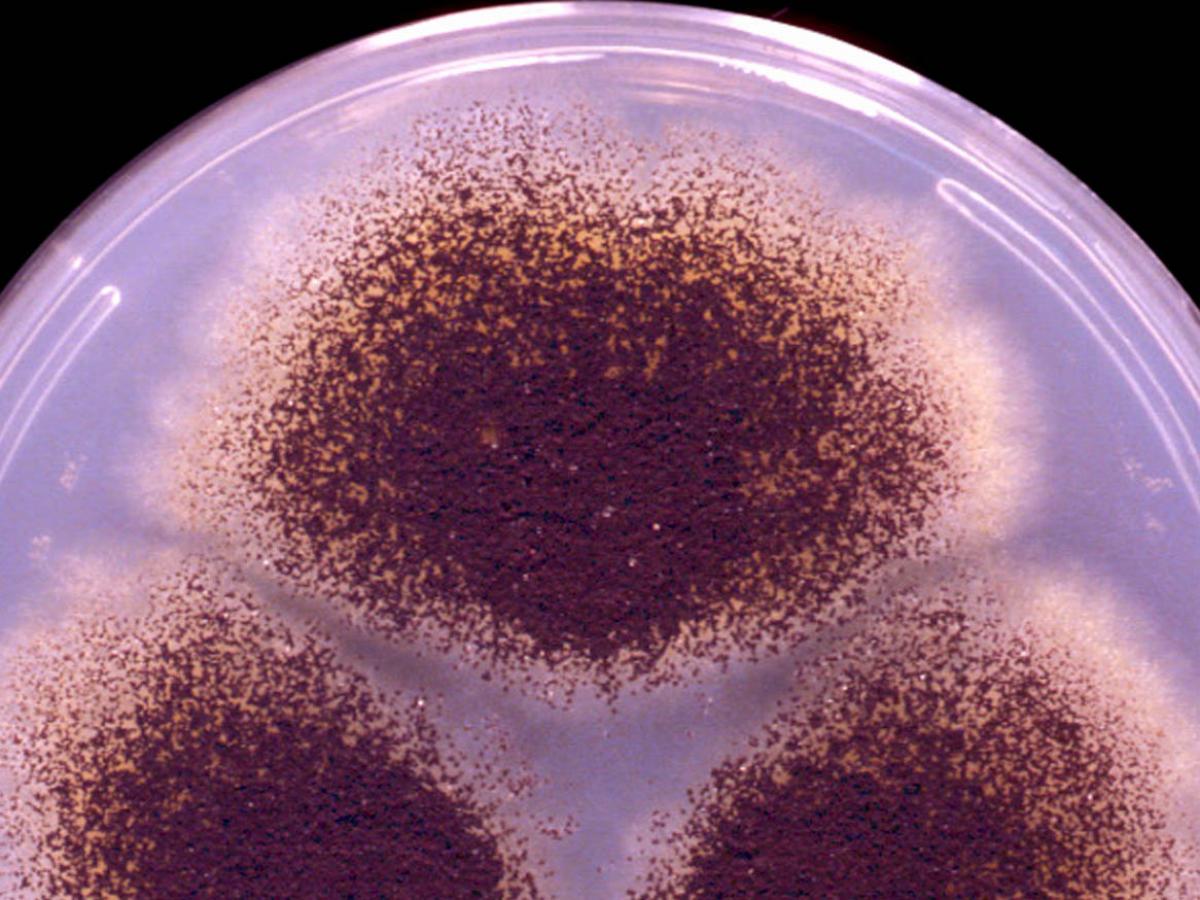
Culture

Unknown 69
Mould identification: a virtual self assessment
Case history
A 51-year old, immunocompromised man presented with chronic unilateral otomycosis which had been unresponsive to a variety of treatment regimens. The patient described with intermittent otalgia and otorrhea and examination revealed a perforation of his left tympanic membrane. Microscopy of debris showed the presence of septate hyphae and the culture below was grown.

Culture
Culture

Microscopy